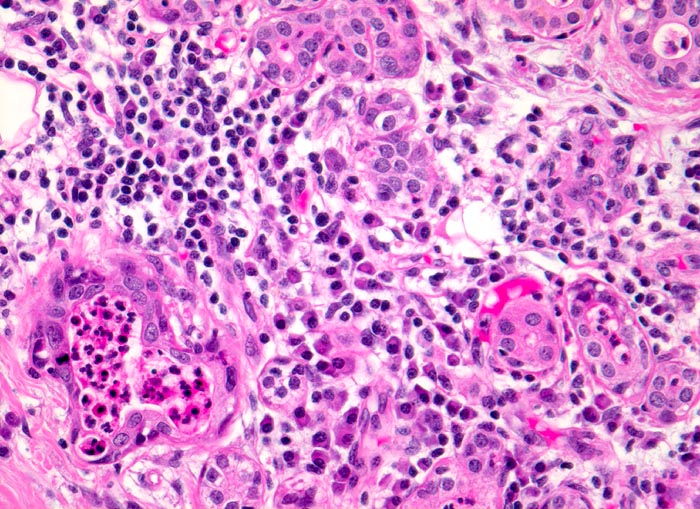

PathoPic – image database / PathoPic ID 3320 - floride chronische Sialadenitis bei Sialolithiasis.
de
Diagnose
floride chronische Sialadenitis bei Sialolithiasis.
Diagnose Gruppe
Entzündung infektiös
Topographie
Glandula submandibularis
Topographie Gruppe
Kopf & Hals, Sinnesorgane
Beschreibung
Drüsenläppchen mit ödematösem lymphoplasmazellulär infiltriertem Stroma. Zwei Drüsenlumina sind leicht erweitert und enthalten Eiter. Die Drüsenazini sind atrophiert.
Klinik
chronische Sialadenitis
Bilder Typ
Histologie
Vergrösserung
200
Alter
52
Geschlecht
unbekannt
Datum
Ersteintrag: 12.11.2001
Update: 21.12.2007